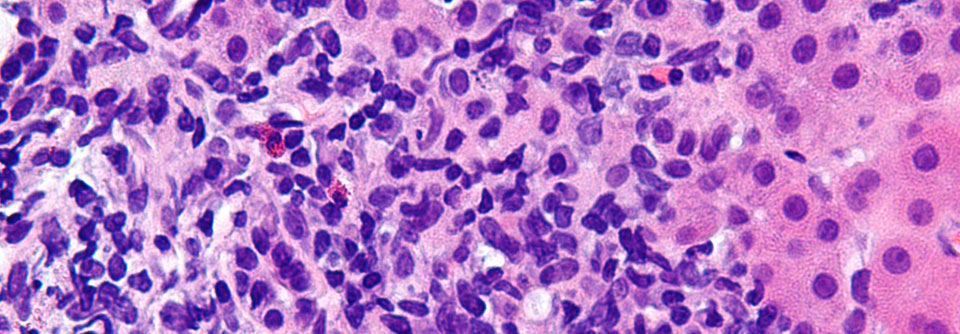
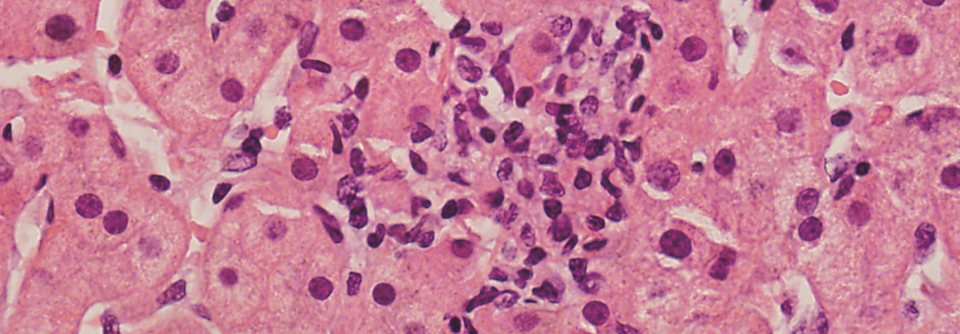

Kasuistik Autoimmunhepatitis oder doch etwas anderes?
 Eine Autoimmunhepatitis kann gerade bei jüngeren Patientinnen und Patienten sehr dramatisch verlaufen und sollte nicht übersehen werden.
© April Tarathai - stock.adobe.com
Eine Autoimmunhepatitis kann gerade bei jüngeren Patientinnen und Patienten sehr dramatisch verlaufen und sollte nicht übersehen werden.
© April Tarathai - stock.adobe.com
Doch manchmal entpuppt sich die vermeintliche Autoimmunerkrankung als etwas ganz anderes – zum Beispiel als medikamenteninduzierte Leberschädigung (DILI, drug-induced liver injury). Diese lässt sich histologisch kaum von einer Autoimmunhepatitis unterscheiden.
Über eine 47-jährige Patientin berichtete Prof. Dr. Dr. Matthias Dollinger, Medizinische Klinik I am Klinikum Landshut. Die kardial vorerkrankte Frau hatte erhöhte Transaminasen. Zur Abklärung erfolgte eine Leberbiopsie. Die Histologie war vereinbar mit einer Autoimmunhepatitis. Eine DILI erschien unwahrscheinlich: Fast alle ihre Medikamente nahm die Patientin bereits seit mehr als einem Jahr ein. Vor vier Monaten war zudem eine Antikoagulation mit Marcumar begonnen worden.
Es erfolgte ein erster Behandlungsversuch mit Steroiden. Dieser führte anfänglich auch zu einem Abfall der Transaminasen. Der Effekt hielt aber nicht an und die Lebererkrankung wurde steroidrefraktär. „Daraufhin haben wir alles nochmal durchgeschaut“, erinnerte sich der Referent. Dabei fiel die doch relativ kurze Zeit seit Beginn der Antikoagulation auf. Marcumar kann in seltenen Fällen eine toxische Leberschädigung hervorrufen. Diese muss nicht gleich zu Beginn der Behandlung auftreten, sondern zeigt sich ggf. erst nach zwei, drei oder wie in diesem Fall nach vier Monaten. Es sei wichtig, an so etwas zu denken und bei steroidrefraktärem Leberschaden alle bisherigen Diagnosen noch mal zu überdenken, riet Prof. Dollinger. Im Falle der beschriebenen Patientin wurde das Medikament abgesetzt und die vermeintliche Autoimmunhepatitis verschwand.
Erneute Biopsie kann Diagnose absichern
Besteht Unsicherheit, ob es sich um eine autoimmun bedingte oder medikamenteninduzierte Leberschädigung handelt, sollte man laut europäischen Leitlinien erst einmal anfangen, mit Hochdosissteroiden zu behandeln. Wenn die Transaminasen nach drei bis sechs Monaten abgefallen sind, kann man die Therapie wieder ausschleichen. „Ich biopsiere dann häufig auch noch mal“, erklärte Prof. Dollinger. „Wenn die Leber dann ausgeheilt ist, war es eine DILI, wenn nicht, ist es eine richtige, rezidivierende Autoimmunhepatitis.“
Quelle: Viszeralmedizin 2024